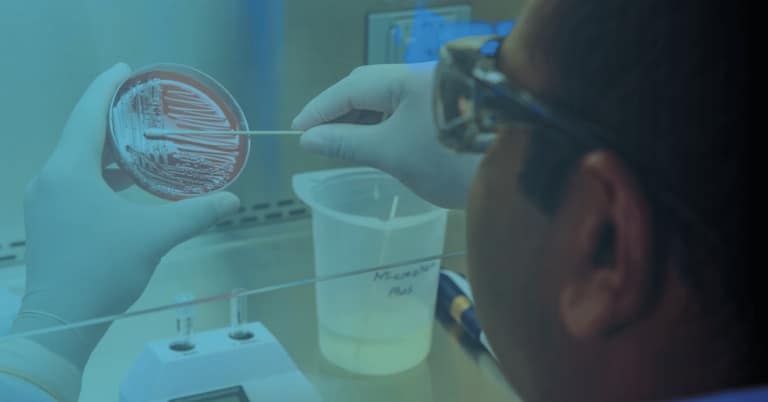
Microbiological Services

Services
Bluezone Scientific offers analytical testing services to include the Microbiological analysis of water, environmental and other samples obtained in the following areas of environmental investigation and monitoring:
- Potable waters
- Process waters
- Surface waters including rivers, surface runoff and lakes
- Underground and well waters
Bluezone Scientific Laboratory is accredited to BS EN ISO 17025:2017 International Standard General Requirements for the Competence of Testing and Calibration Laboratories for the tests identified on the UKAS schedule of accreditation.
By complying with this International Standard, Bluezone Scientific demonstrate they operate in accordance with the principles of ISO 9001 International quality management standard.
Services
Legionella Analysis
Detection, enumeration and identification of Legionella spp and Legionella pneumophila serogroup 1, serogroup 2-14 and Legionella spp.

Pseudomonas aeruginosa
Isolation, enumeration and confirmation of Pseudomonas aeruginosa.

Coliform / E.coli
Lab Test
Isolation, enumeration and confirmation of Coliform and E.coli bacteria.

Colony Counts
Testing
Determination of viable colony counts.
Need help with our services?
Contact us to find out more about our services and how we can help.
Bluezone Scientific is an independent laboratory offering a variety of UKAS accredited water testing analysis. Our competent team provide rapid turnaround times, technical expertise and an established logistical network. All underpinned by our user-friendly LIMS software that gives our clients access to their results 24/7.


